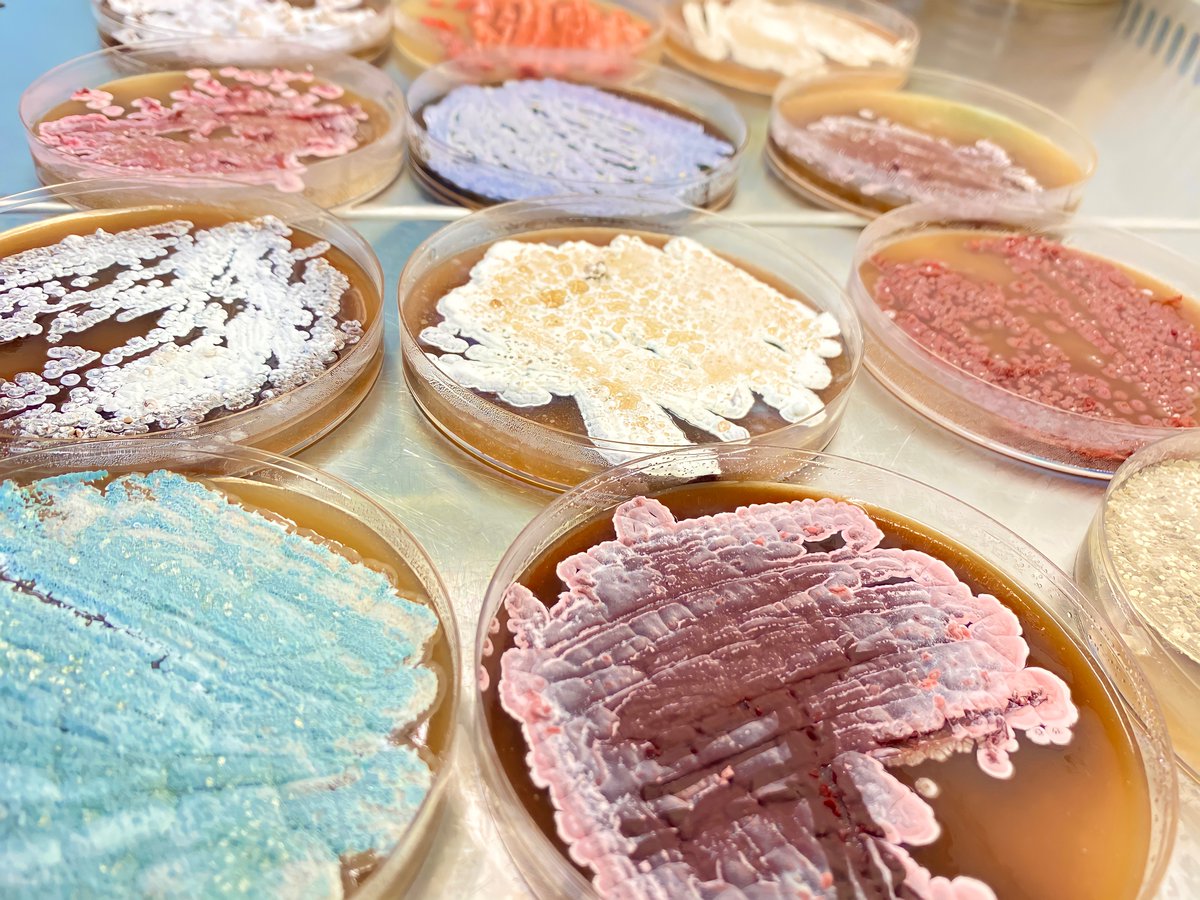
Science à la pelle tweet media
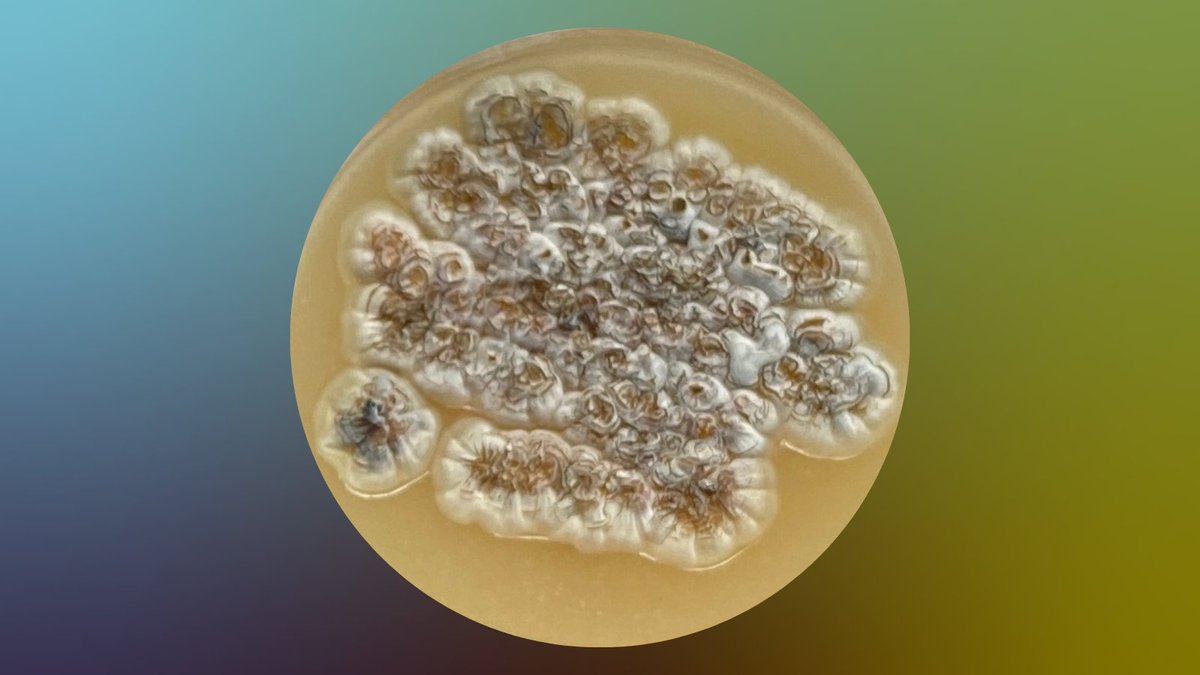
Science à la pelle tweet media
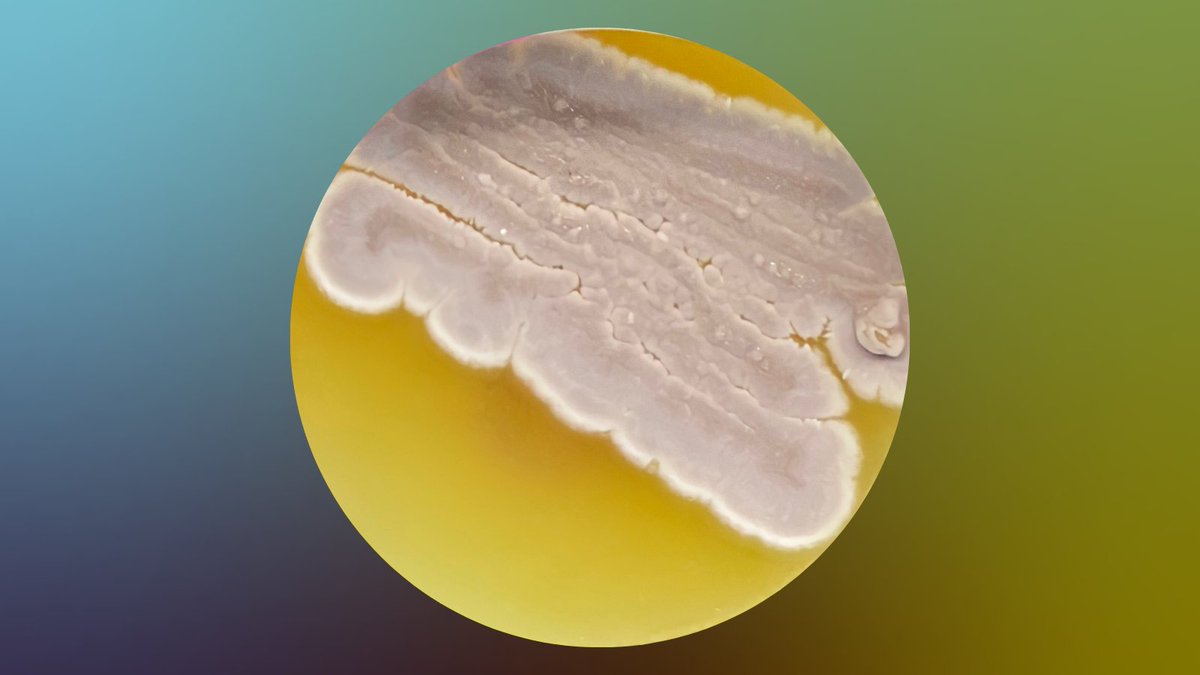
Science à la pelle tweet media

تغريدة مثبتة
Science à la pelle
112 posts

Science à la pelle
@ScienceALaPelle
Envoie-nous des échantillons de sols🌱 pour nous aider à trouver les médicaments de demain💊 Projet de science citoyenne @Inserm @Univ_Paris @lpiparis_🧪🧫🧬
France انضم Mayıs 2022
393 يتبع182 المتابعون

Ca y est la campagne de récolte de sols est terminée 🎉 Merci à toutes et tous pour votre soutient, vos questions et votre participation 💚
Nous vous tenons au courant du nombre final d'échantillons que nous avons reçus prochainement !
#ScienceCitoyenne

Français

Allez voir la carte intéractive mise à jour sur notre site science-a-la-pelle.fr/results
#ScienceCitoyenne #SousLesPavésLaScience #LesDiggersDeMicrobes #LifeDigging #DropTheMicrobe #EverydayImShoveling #LesMainsDansLaTerre #LesBactériesSauventDesVies
Français
Science à la pelle أُعيد تغريده

#sciencesparticipatives - J-4🕥
Le projet @ScienceALaPelle a besoin de vous !
Jusqu'au 30 août ✨, envoyez vos échantillons de sols pour aider l'équipe de #recherche à découvrir les médicaments de demain ! 👩🔬👨🔬
👏science-a-la-pelle.fr/projet
@univ_paris_cite @Inserm @research_lpi
Learning Planet Institute@lpiparis_
#RECHERCHE - A la découverte de @ScienceALaPelle 👀 Pourquoi le projet de recherche Science à la pelle a besoin des citoyen-ne-s ? La chercheuse Helena Shomar revient sur le rôle des #sciencesparticipatives dans ce projet ! @Inserm @univ_paris_cite
Français

la newsletter📧de la semaine est en ligne ! si vous voulez la lire 🔗 mailchi.mp/0edf61124230/n…
Vous y trouverez de superbes photos de nos cultures de Streptomyces et des infos sur la suite du projet !

Français

l'app - web.mindlogger.org/join/eac6bced-…
le formulaire - framaforms.org/enregistrement…
Français

La fin de récolte approche à grands pas et nous avons presque 1000 échantillons !
N'oubliez pas d'enregistrer les données de vos échantillons sur l'app ou le formulaire en ligne avant de nous les envoyer 📲
#ScienceCitoyenne #DropTheMicrobe
#LesBactériesSauventDesVie

Français

📸1 : souche issue d'un échantillon provenant du Lot-et-Garonne
📸2 : souche issue d'un échantillon provenant du Gard
photos prises par Yaganeh
#LesBactériesSauventDesVies #DropTheMicrobe
#ScienceCitoyenne #SousLesPavésLaScience #LesDiggersDeMicrobes #MedicamentsDesSols
Français

l'app - web.mindlogger.org/join/eac6bced-…
le formulaire - framaforms.org/enregistrement…
Français

C'est la dernière ligne droite ! Allons nous atteindre les 1000 échantillons ? N'oubliez pas d'enregistrer les données de vos échantillons sur l'app ou le formulaire en ligne avant de nous les envoyer 📲📨
#ScienceCitoyenne #DropTheMicrobe

Français

Si vous n'avez pas accès à internet en haut de la montagne 🏔️ ou au fin fond de la grotte où vous échantillonnez nous avons la solution !
#FAQsciencealapelle #WeGotYourBact #ScienceCitoyenne #LesMainsDansLaTerre #LesBactériesSauventDesVies


Français